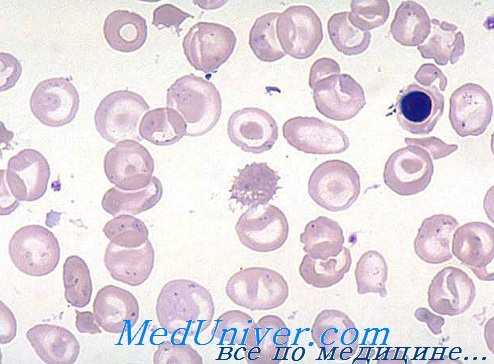
мазок крови при бета-талассемии

Клиника бета-талассемии - признаки
Добавил пользователь Skiper Обновлено: 31.10.2025
Лабораторная диагностика бета-талассемии - анализы
При тяжелой талассемии анемия неизменно тяжелая и резко гипохромная, при этом значения гемоглобина колеблятся от 5 до 7 г/100 мл крови, а показатели гематокрита и численности красных кровяных клеток соответственно уменьшаются. Постоянные эритроцита НЕМ и СНЕМ меньше нормы, соответственно недостаточности гемоглобина в эритроцитах. Вместе с тем, показатель РОЭ колеблется в соответствии с недостаточностью фолиевой кислоты и связанным с ней вторичным макроцитозом.
Мазок периферической крови характерен и с самого же начала исследования подсказывает диагноз. Гипохромия резко выражена, ей сопутствует анизопойкилоцитоз высокой степени. Многочисленные точечные и частые капельные гематии и овалоциты, наряду с большим числом красных кровяных телец искаженного очертания и шизоцитов различной формы и величины, в целом характеризуют мазок при анемии Кули.
Звездочкообразные гематии с подвернутыми краями напоминают «мексиканскую шляпу», при этом иногда они макромегалоцитные (12—15 u). В случаях очень низкого показателя гемоглобина отдельные гематии как бы лишены содержания, в связи с чем принимают аспект «эритроцитной тени». Часто отмечается наличие красных кровяных телец с кольцами Cabot, телец Jolly и базофильными точками. Неизменно присутствие эритробластов (5—20/100 лейкоцитов), при этом, после удаления селезенки, их численность в несколько раз больше лейкоцитов (300—500/100 лейкоцитов).
Выраженная полихроматофилия мазка отражает повышенный ретикулоцитоз (5—15%).
При легкой талассемии анемия умеренная (гемоглобин от 7 до 10 г/100 мл) или небольшая, причем в формах отягчения могут наблюдаться нормальные значения гемоглобина. Степень эритроцитной беспорядочности значительно меньше, чем при тяжелой талассемии. Мазок периферической крови отражает общий аспект микроцитной гипохромной анемии. Тем не менее пойкилоцитоз, наличие звездочкообразных и точечнобазофильных красных кровяных телец делает возможным отличить это заболевание от однородной микроцитно-гипохромной картины железодефицитной анемии.
Небольшая полихроматофилия соответствует слегка увеличенной численности ретикулоцитов (2—5%). Эритробласты редкие (1—2 на несколько сот лейкоцитов) или, как это бывает в большинстве случаев, просто отсутствуют.
Умеренный лейкоцитоз постоянное явление при тяжелой талассемии (10 000—20 000/мм3), ему нередко сопутствует отклонение влево лейкоцитной формулы. У большинства больных наблюдается и небольшой рост показателя численности тромбоцитов. В принципе, при легких формах, число лейкоцитов и тромбоцитов укладывается в норму или у высшего предела.
Мазок при бета-талассемии
Косвенный билирубин увеличен (1—3 мг/100 мл), показатели уробилиногена в моче и выделения стеркобилиногена с испражнениями — весьма высокие. При легкой талассемии все эти признаки разрушения красных кровяных клеток существуют, но в значительно сокращенном виде в зависимости от клинической формы и степени расплавления крови.
Осмотическая устойчивость эритроцитов в гипотонном солевом растворе почти неизменно повышена, общее расплавление крови часто отмечается при концентрации примерно 0,2 г NaCl/100 мл или даже меньше в случае выраженного платицитоза. Для диагностирования талассемии реакция весьма полезна, но отнюдь не патогномонична. Отмечаются случаи железодефицитиой анемии с высокой осмотической устойчивостью, подобно случаям талассемии-отягчение, при которой показатели близки к норме.
Сидервмия, общая способность связывания сидерофилина (СС), латентная способность (ЛС), коэффициент насыщения (КН) сидерофилина железом выявляют степень нагрузки организма железом. В большинстве случаев тяжелой талассемии СС меньше нормы (300—330 мкг), показатель сидеремии всегда повышен и КН колеблется от 60 до 100%, подобно тому как наблюдается при гемохроматозе. Окраска на определение костномозгового гемосидерина выявляет увеличенное количество последнего в макрофагах и значительный процент сидеробластов.
При легкой талассемии сидеремия несколько повышена или нормальна, причем в отдельных случаях показатель СС несколько занижен а значения КН сидерофилина укладываются в перделы от 33 до 60%. Вообще процент сидеробластов превышает норму. Определение сидеремии, СС, КН и костномозгового железа особо полезны при дифференциальной диагностике с гипохромной железодефицитиой анемией.
В условиях тяжелой талассемии костный мозг отличается выраженной гиперплазией с явным преобладанием эритробластического ряда (Г/Э = 1/4—1/8). В случае недостатка фолиевой кислоты некоторые эритробласты приобретают мегалобластовидный аспект. При легкой талассемии костномозговой мазок выявляет наличие обильной клеточной массы с умеренным преобладанием эритробластического ряда. В принципе исследование костного мозта не обязательно для постановки диагноза, тем не менее оно полезно для определения запасов железа, в основном при легкой талассемии с электрофорезом гемоглобина в пределях нормы или при осложнениях с хронической кровоточивостью и недостатком железа.
Электрофорез гемоглобина основной способ для уточнения диагноза бета-талассемии. Тяжелая талассемия или анемия Кули характеризуется весьма высоким показателем гемоглобина F (N > 2% у детей старше 1 года), составляющим 20—90% всего гемоглобина, в остальной части отмечается наличие гемоглобин А и нормальные или завышенные значения гемоглобин А2. Наиболее часто значения гемоглобин F составляют 30—60%. В случаях гомозиготной бета-талассемии вида дельта-бета все количество гемоглобина состоит лишь из вида F, при полном отсутствии видов А и А2. Значения Гб в результате электрофореза следует сопоставить со значениями химического теста на определение щелочноустойчивого гемоглобина, в целях исключения аномального гемоглобина, электрофоретическая миграция которого может оказаться одинаковой с гемоглобином F.
Гетерозиготная бета-талассемия характеризуется ростом показателя гемоглобина А2 и/или гемоглобина F, в процентном выражении. Большинство случаев гетерозиготной талассемии (примерно 90%) относятся к виду I при этом показатель гемоглобина А2 колеблется в пределах от 4 до 6% (N > 3%). Значения от 3 до 4%, в частности от 3 до 3,5% следует толковать осторожно и сопоставлять с результатами остальных исследований. Примерно в 50% случаев гетерозиготной бета-талассемии, с высоким показателем гемоглобина А2, отмечается и слегка повышенный показатель гемоглобина F (2—5%), причем для их определения применяется тест на устойчивость к щелочам.
Бывают случаи легкой бета-талассемии, осложняющиеся недостатком железа (повторные роды, хроническая кровоточивость и пр.), при которых значения гемоглобина А2 при электрофоретическом исследовании укладываются в норму. После проведения железотерапии повторный электрофорез выявляет рост показателя гемоглобина А2 за пределы нормы.
Случаи гетерозиготной бета-талассемии, характеризующиеся ростом лишь гемоглобина F редки (среди нашего населения примерно 10% всех гетерозиготов), при этом соответствующий показатель составляет примерно 2—30%, наиболее часто 5—15%; у подобных больных гемоглобин А2 нормальный или заниженный, остальную долю — составляет гемоглобин А. Такие случаи следует отличать от физиологических или патологических состояний с высоким показателем гемоглобин F, таких как, беременность, бирмеровская и сидероакрестическая анемия, лейкемия и пр.
Диагностирование бета-талассемии относительно несложное. Проявление болезни в детстве, клинические и гематологические признаки тяжелой гемолитической анемии подсказывают диагноз наследственной гемолитической анемии. Аспект мазка периферической крови исключает остальные виды наследственной гемолитической анемии, в первую очередь врожденного сфероцитоза. Электрофорез и определение щелочноустойчивого гемоглобина выявляют весьма высокий показатель гемоглобина F, и тем самым подтверждают диагноз.
При легкой форме бета-талассемии клиническое и гематологическое исследования менее убедительны. Наиболее частая ошибка заключается в определении заболевания как гипохромная железодефицитная анемия. Однако пойкилоцитоз, звездочкообразные красные кровяные тельца, базофильноточечные гематии, равно как и признаки расплавления крови свидетельствуют о наличии легкой формы талассемии.
Высокие показатели сидеремии и костномозгового гемосидерина лишний раз подтверждают это предположение. Диагноз подтверждается электрофорезом и определением щелочноустойчивого гемоглобина, поскольку эти исследования выявляют высокие показатели гемоглобина А2 и/или гемоглобина F. Исследования в семейном плане подтверждают наследственный характер заболевания. Так, при тяжелой талассемии, как у отца, так и у матери выявляется наличие легкой талассемии, в то время как при легкой форме этого заболевания, по меньшей мере у одного из них.
Редактор: Искандер Милевски. Дата обновления публикации: 18.3.2021
Клиника бета-талассемии - признаки
бета-Талассемия (анемия Кули) - причины, классификация
бета-Талассемия [синонимы: анемия и отягчение CooJey, средиземноморская анемия, наследственный лептоцитоз (точечноклеточная анемия), семейная микроцитемия] представляет собой талассемический синдром, в котором генетическое поражение обусловливает частичный или полный блокаж синтеза полипептидных цепей бета или цепей бета и сигма.
В отдельных формах бета-талассемии генетический сдвиг вызывает блокаж синтеза лишь цепей бета. Это составляет бета-талассемию типа А2 или бета-талассемию типа I. В иных формах генетическая аномалия нарушает синтез цепей бета и дельта; такие случаи составляют бета-талассемию типа F или дельта-бета-талассемию или бета-талассемию типа II.
Каждый из этих типов подразделяется, соответственно частичной (бета+ или дельта-бета+) или полной (бета° или дельта-бета°) репрессии синтеза.
Классификация генетических форм бета-талассемии приведена ниже в таблице.

Симптомокомплексы бета-талассемии. Тал+ и Тал° виды бета-талассемии с частичным и соответственно полным блокированием цепей бета
Этиология (причины) бета-талассемии
бета-Талассемия генетическое заболевание, обусловливаемое мутацией генов, которые контролируют синтез гемоглобина. Среди всех заболеваний гемоглобина бета-талассемия находится на первом месте, как с точки зрения частоты и численности случаев заболевания, так и тяжести формы у гомозиготов.
Случайно болезнь выявляется среди любого населения земного шара, тем не менее, в определенных зонах, высокий показатель частоты заболевания создает поистине социально-медицинские проблемы.
Зона максимальной частоты опоясывает земной шар от средиземноморского через Средний Восток до Дальнего Востока. Среди европейских стран по частоте заболевания на первых местах значатся Италия и Греция. При этом в первой из них частота более 15% в области дельты реки Падуа, на юге страны и в Сардинии, в то время как во второй — показатель частоты неодинаков, но описаны зоны, в которых частота достигает 10%.

Соотношение генетических и клинических форм при бета-талассемии
Другим очагом большой заболеваемости бета- и а-талассемией считается юго-восточная Азия, в частности Таиланда, где показатель частот колеблется от 4,8 до 10%. У нас в стране проведенные исследования в отдельных местностях Олтении, Мунтении и южной Молдовы на более 10 000 случаев показали, что заболевание составляет в среднем 0,4%.
Высокий показатель частоты заболевания среди отдельных групп населения объясняется частным преимуществом гетерозиготов к определенным средовым условиям. Так, зоны максимальной частоты талассемии совпадают с зонами, в которых малярия составляет или была в прошлом эндемическое заболевание. Отдельные данные свидетельствуют о способности талассемии создавать некоторую устойчивость к малярии.
Вопреки немалому числу работ, посвященных уточнению места развития талассемической мутации и генетического механизма этого заболевания, проблема еще неполностью выяснена.
По результатам недавно проведенных исследований утверждается, что сокращение синтеза цепей бета при бета-талассемии последствие уменьшения количества не бездействующей, а специфической для этих цепей иРНК, хотя обусловливающий это сокращение генетический механизм еще не вскрыт. Также не уточнено составляет ли бета-талассемическая мутация аллелу бета-структурного локуса или ее действие протекает на очень близком к последней уровне.
С клинической точки зрения бета-талассемия протекает с различной тяжестью, обусловливаемой, в первую очередь, гомо- или гетерозиготным состоянием.
В принципе гомозиготное состояние (тяжелая талассемия или анемия Кули) обретает форму тяжелой гемолитической анемии, прогрессивного течения и летального исхода уже на первом или втором десятке лет жизни, в то время как гетерозиготное состояние (легкая талассемия) представляет собой относительно легкое заболевание с примерно нормальной продолжительностью жизни данного больного.
Однако отдельные случаи не могут быть отнесены к той или иной из этих двух клинических форм. Термин "thalassemia intermedia" (промежуточная талассемия) клиническое название, включающее формы гомозиготной талассемии с легким течением и гетерозиготные формы, тяжесть которых приближается к клиническому проявлению анемии Кули. Доброкачественные формы легкой клинически бессимптомной талассемии — истинные формы отягчения — соответствуют понятию "thlassemia minima" (малая талассемия))
Начало бета-талассемии. Тяжелая талассемия проявляется на ранних сроках, при этом заболевание выявлявется уже со 2-ой половины первого года жизни. Первыми признаками являются бледность, задержка развития и прогрессивный рост живота за счет увеличения размеров печени и селезенки. Со временем клиническая картина дополняется характерными для анемии Кули признаками.
Выраженная бледность покровов и слизистых оболочек, которой сопутствует разная степень желтухи или поджелтухи с самого же начала привлекает внимание.
Костные сдвиги, обусловливаемые острой костномозговой гиперплазией черепнолицевых костей на рентгенологическом снимке приобретают аспект «щеткообразного черепа», что в клиническом плане проявляется как "facies mongoloidus" (впалый и расширенный корень носа, выпуклые лобные бугры, гипертрофия верхней челюсти, дефекты вживления зубных рядов с тенденцией к обнажению верхнего ряда). Во всех случаях рентгенограмма выявляет обобщенный остеопороз.

В полых костях рентгенологическое исследование обнаруживает резкое сужение коркового слоя и расширение мозговых полостей. Спленомегалия резко выражена, при этом она наблюдается в 100% случаев. Увеличение селезенки прогрессирует с течением заболевания и во многих случаях воспроизводит аспект пораженной опухолью селезенки с четким растяжением живота. В любом случае отмечается определенная степень гепатомегалии, обостряющейся после удаления селезенки.
Хроническая язва лодыжек встречается реже, чем при сиклемии, причем развивается она в основном у больных достигающих подросткового или зрелого возраста. Задержка развития отмечается у большинства детей, она принимает выраженный характер на втором десятилетии жизни, при этом нередко сопровождается задержкой появления вторичных половых признаков.
Гетерозиготная бета-талассемия или легкая талассемия составляет обычно обнаруживаемую у взрослых форму болезни. Клинические проявления значительно колеблятся — от формы бессимптомного отягчения (thalassemia minima) вплоть до умеренной гемолитической анемии с сопутствующими желтухой или поджелтухой белковой оболочки и спленомегалией (thalassemia intermedia).
При легких формах талассемии больной не обращается к врачу, вот почему их диагностирование носит либо случайный характер при периодическом медицинском обследовании, либо в условиях скрининга. Наиболее частую клиническую форму легкой талассемии составляет микроцитная гипохромная анемия. У большинства страдающих подобным заболеванием, и которые в прошлом получали большие дозы железа, болезнь рассматривается исходно как железодефицитная гипохромная или «упорная » анемия.
При легкой форме талассемии клиническая симптоматология скудная и нехарактерная. Бледность с желтоватым оттенком наблюдается в большинстве случаев заболевания и может отсутствовать лишь при очень легких формах. Поджелтуха или желтуха белковой оболочки отмечается в основном при хроническом гемолизе, причем интенсивность колеблется в зависимости от степени процесса расплавления крови.
Спленомегалия обнаруживается примерно в 50% случаев, при этом селезенка умеренно увеличена и прощупывается либо у реберного края либо немного выступает за его пределы. В принципе, по величине, печень укладывается в норму, однако у многих больных, при надавливании, отмечается чувствительное или даже болезненное место в желчном пузыре, что свидетельствует о его хроническом воспалении или желчнокаменной болезни. Изменения в костях незначительны и нехарактерны или порсто отсутствуют.
Естественно отнесение подобных случаев к описанным клиническим формам носит относительный характер, в частности для гетерозиготов, поскольку, во-первых, известны случаи перехода от одной клинической формы к другой, а во-вторых — определенный случай приобретает ту или иную клиническую форму в зависимости от течения болезни и отдельных, воздействующих на него усугубляющих факторов.
Гемоглобинопатии
Гемоглобинопатии – это группа тяжелых наследственных заболеваний крови, обусловленных нарушением структуры гемоглобина или снижением синтеза одной и более глобиновых цепей. Клиническая картина крайне разнообразна. Общими симптомами являются гемолитическая анемия, увеличение селезенки, поражение костей. Диагностика осуществляется с помощью микроскопии мазка периферической крови, электрофореза гемоглобина, генетических исследований. Для лечения применяют переливание компонентов крови, препараты гидроксимочевины, инфузионную терапию. У тяжелых пациентов выполняется спленэктомия, аллотрасплантация стволовых клеток.
МКБ-10


Общие сведения
Гемоглобинопатии – ряд врожденных гемолитических анемий, характеризующихся изменением аминокислотной последовательности гемоглобина или подавлением образования цепей глобина. Данные патологии нередко заканчиваются летально уже в раннем детском возрасте. Известно около 50 видов гемоглобинопатий. Самыми частыми и опасными для жизни считаются серповидно-клеточная анемия (СКА), талассемии. Гемоглобинопатии распространены на территории Центральной Африки, Южной Азии и наблюдаются преимущественно у лиц негроидной расы. Талассемии также встречаются в странах Средиземноморья. Ежегодно рождается около 350000 детей с дефектами гемоглобина.

Причины гемоглобинопатий
Гемоглобинопатии относятся к аутосомно-рецессивным генетическим заболеваниям. Качественные гемоглобинопатии развиваются вследствие мутаций генов, ответственных за синтез определенных аминокислот в бета-цепи глобина. В результате происходит замена одной аминокислоты на другую (глутаминовой кислоты на валин, лизин и пр.). Это приводит к образованию аномального гемоглобина, гораздо менее растворимого, чем нормальный гемоглобин А, придающего красным кровяным тельцам иную форму (мишеневидную, серповидную), что нарушает их функции и уменьшает продолжительность жизни.
Количественные гемоглобинопатии обусловлены мутацией генов, которые кодируют целую цепь глобина (чаще альфа и бета). При этом сдвигается баланс между глобиновыми цепями – при недостаточном синтезе альфа-цепей возникает избыток бета-цепей, и наоборот. Уменьшаются размеры эритроцитов, в них снижается содержание гемоглобина, а мембрана становится более подверженной различным повреждениям.
Существуют факторы, провоцирующие тяжелые приступы (кризы). К ним относятся обезвоживание, переохлаждения, инфекции, сопровождающиеся высокой лихорадкой. У женщин обострения нередко развиваются на фоне беременности. Но главный патологический стимул качественных гемоглобинопатий – уменьшение концентрации в крови кислорода (гипоксия). Это может произойти, например, при подъеме на большую высоту (восхождение на гору, полет на самолете), где снижено парциальное давление кислорода воздуха, или при тяжелых болезнях дыхательной системы (пневмонии).
Патогенез
Гемоглобинопатии имеют сходные патогенетические механизмы. Измененная структура гемоглобина предрасполагает к интенсивному гемолизу. Длительно текущая анемия способствует компенсаторной гиперплазии костного мозга. Возникает деформация костей черепа, искривление позвоночника. Развиваются экстрамедуллярные очаги кроветворения, приводящие к увеличению размеров печени и селезенки (гепатоспленомегалии). Вследствие спленомегалии наступает гиперспленизм – усиленная деструкция красных клеток крови синусоидами селезенки.
Из-за регулярного гемолиза эритроцитов печень секретирует в желчь большое количество билирубина, что создает условия для образования камней желчного пузыря. У больных гемоглобинопатиями часто возникает перегрузка железом, как за счет постоянных переливаний крови, так и из-за повышения абсорбции железа желудочно-кишечным трактом. Большое количество железа в тканях усиливает процессы перекисного окисления липидов, что повреждает различные органы.
При качественных гемоглобинопатиях под влиянием сниженного содержания кислорода в крови молекулы нерастворимого аномального гемоглобина растягивают мембрану эритроцитов, что приводит к изменению их формы. Деформированные эритроциты хуже переносят кислород, а также способны приклеиваться к сосудистому эндотелию, тем самым закупоривая мелкие сосуды, вызывая тромбозы, окклюзии и инфаркты.
Классификация
Гемоглобинопатии подразделяются на качественные, обусловленные нарушением структуры (последовательности аминокислот) гемоглобина, и количественные, характеризующиеся снижением образования глобиновых цепей. Качественные гемоглобинопатии представлены следующими формами:
- Серповидно-клеточная анемия (Гемоглобинопатия S). Наиболее частый вид. Подразделяется на гомозиготную форму (собственно СКА) с яркой клинической симптоматикой и гетерозиготное носительство (серповидно-клеточную аномалию), имеющее бессимптомное или легкое течение.
- Гемоглобинопатия С. Клиника схожа с СКА, но менее выражена. Отличается большей степенью спленомегалии, чем при СКА.
- ГемоглобинопатияCS (Африканский ревматизм). По течению напоминает СКА. Преобладают приступообразные костно-суставные боли.
- Гемоглобинопатии Е иD. Протекают с небольшой гемолитической анемией.
- Наследственная метгемоглобинемия. При этой разновидности под влиянием различных факторов образуется окисленная форма гемоглобина – метгемоглобин, который более стойко связывается с кислородом и не отдает его тканям.
- Анемия, вызванная носительством нестабильных гемоглобинов. Это доброкачественная патология, при которой возникает незначительная гемолитическая анемия после приема сульфаниламидных препаратов.
К количественным аномалиям гемоглобина относят:
- Бета-талассемии. Наиболее распространенный вариант. Подразделяется на малую талассемию (гетерозиготное носительство с бессимптомным течением или легкой гемолитической анемией) и большую талассемию (анемию Кули) с развернутой тяжелой клинической картиной.
- Альфа-талассемии. Течение может быть различным в зависимости от количества мутантных генов. В основном сходны с гетерозиготной бета-талассемией.
- Синдром водянки плода c гемоглобином Барт (Hb Bart’s). Наиболее тяжелый вид альфа-талассемии. Ребенок погибает внутриутробно.
- ГемоглобинопатиюH. Благоприятная малосимптомная форма альфа-талассемии.
- Бета-дельта-талассемии. Практически неотличима от бета-талассемии.
- ГемоглобинопатиюLepore. Эта форма развивается вследствие слияния бета-цепей глобина и схожа с бета-талассемией.

Симптомы гемоглобинопатий
Клиническая картина гемоглобинопатий разнообразна. Гетерозиготные больные имеют либо бессимптомное, либо легкое течение. Гомозиготные формы начинают себя проявлять уже с раннего детства (6 месяцев - 1 год). Общая симптоматика включает признаки гемолитической анемии (бледность, желтушность кожи и слизистых, увеличение селезенки), патологию развития скелета – башенный череп (четырехугольный), уплощенная переносица, искривленный позвоночник.
Из-за повышенной секреции билирубина в желчь могут беспокоить симптомы желчнокаменной болезни уже в детском возрасте – тяжесть или ноющие боли в правом подреберье, приступы желчной колики, обесцвечивание кала. На коже голеней часто возникают длительно незаживающие язвы. Для болезней с дефектом в структуре гемоглобина характерно кризовое течение. Самые тяжелые приступы, нередко заканчивающиеся летально, встречаются при серповидно-клеточной анемии.
Вазоокклюзивный криз
Наиболее типичный. Происходит закупорка мелких сосудов различных органов. Дети испытывают боли в длинных трубчатых костях, у них отекают кисти, стопы, что затрудняет движения лучезапястных, голеностопных суставов (hand-foot синдром). Микротромбозы сосудов кишечника вызывают абдоминальные боли. У молодых мужчин нередко развивается приапизм, впоследствии приводящий к эректильной дисфункции. Кризу сопутствует лихорадка, тахикардия, потливость.
Гемолитический криз
При гемолитическом кризе происходит массивное разрушение красных телец с резким снижением содержания гемоглобина, эритроцитов в крови. Усиливается имеющаяся желтушность, бледность кожных покровов, слизистых, возникают лихорадка, поясничные и абдоминальные боли, присоединяются симптомы снижения артериального давления (головокружение, обмороки). Моча приобретает темный цвет за счет большого количества гемоглобина.
Секвестрационный криз
Во время секвестрационного криза также стремительно падает уровень гемоглобина. Но это происходит не из-за гемолиза, а вследствие венозного тромбоза и скопления большого количества крови в расширенных синусоидах печени и селезенке, что и приводит к обеднению общего кровотока. Кроме симптомов тяжелой анемии по причине выраженной гепатоспленомегалии появляются сильные и распирающие боли в левом и правом подреберье.
Апластический криз
Достаточно редкая форма криза. Она развивается при инфицировании парвовирусом В19, который способен угнетать костномозговое кроветворение. Это сопровождается стремительным (но обратимым) снижением концентрации не только эритроцитов, но и всех других клеток периферической крови (лейкоцитов, тромбоцитов). Поэтому к признакам анемии присоединяется геморрагический синдром (кровотечения из носа, десен), различные инфекции (в основном ОРВИ).
Осложнения
Общими осложнениями гемоглобинопатий считаются ЖКБ, патологические переломы длинных трубчатых костей. Гетерозиготные формы редко сопровождаются неблагоприятными событиями, так как имеют легкое течение. При количественных гемоглобинопатиях из-за отложения избыточного количества железа во внутренних органах развивается сердечная недостаточность, цирроз печени, сахарный диабет 2 типа.
Качественные патологии гемоглобина характеризуются широким спектром неблагоприятных последствий. Наиболее опасными считаются эмболия легочных сосудов, инфаркт миокарда, ОНМК, которые примерно у 10% пациентов приводят к смерти. Закупорка микрососудов, питающих кости, ведет к асептическому некрозу головки бедренной кости (АНГБК). Вследствие постоянных инфарктов селезенки возникает функциональный асплезнизм, из-за чего часто развиваются бактериальные инфекции (бронхиты, пневмонии) с тяжёлым течением, нередко с летальным исходом.
Диагностика
Курацией больных с гемоглобинопатиями занимаются врачи-гематологи, генетики. Во время общего осмотра обращается внимание на цвет кожных покровов (бледность, желтуха), конституциональные нарушения (задержку нервно-психического, физического развития ребенка, аномалии строения скелета). Дополнительное обследование включает:
Гемоглобинопатии дифференцируют с другими врожденными гемолитическими анемиями (мембранопатиями, ферментопатиями, микросфероцитарной анемией Минковского-Шоффара). Постоянные тромбозы нужно дифференцировать от различных тромбофилий. Перегрузку железом следует отличать от наследственного гемохроматоза. Анемия, оссалгии требуют исключения злокачественных миелопролиферативных заболеваний.
Лечение гемоглобинопатий
Людям, страдающим гемоглобинопатиями, требуется проведение сложной многокомпонентной терапии, поэтому все пациенты с гомозиготными формами подлежат обязательной госпитализации в гематологический стационар. Больным с гетерозиготными формами лечение не показано. Основные принципы ведения качественных и количественных патологий гемоглобина несколько отличаются друг от друга.
Консервативная терапия
Подбор консервативной терапии производится с учетом вида гемоглобинопатии, течения заболевания, наличия тех или иных осложнений. Оценивается как клиническая симптоматика, так и лабораторные данные (главным образом, показатели красной крови). Выделяют следующие направления лечения:
- Купирование кризов. При вазоокклюзивных кризах используются обезболивающие препараты (нестероидные противовоспалительные средства), а при выраженном болевом синдроме - наркотические анальгетики. Также для подавления преципитации деформированных эритроцитов назначаются ингаляции кислородом, пероральная или внутривенная регидратация.
- Предупреждение кризов. Для постоянного приема больным качественными гемоглобинопатиями назначается гидроксимочевина. Этот препарат стимулирует образование фетального гемоглобина, подавляющего экспрессию гена, ответственного за синтез аномальных нерастворимых гемоглобинов, что уменьшает склонность эритроцитов к деформации, снижает частоту кризов.
- Терапия осложнений. Инфекционные осложнения до получения результатов бактериологических исследований лечат антибактериальными препаратами, активными против пневмококка, гемофильной палочки, менингококка. Используются антибиотики из группы пенициллинов (амоксициллин). При развитии тромбозов применяются антикоагулянты (низкомолекулярные, нефракционированные гепарины).
- Гемотрансфузии. Так как анемия у пациентов с количественными патологиями гемоглобина всегда тяжелая, основу лечения составляют регулярные гемотрансфузии. Людям, страдающим качественными гемоглобинопатиями, переливания крови проводятся только при секвестрационных, гемолитических, а также апластических кризах.
- Борьба с перегрузкой железа и дефицитом фолатов. Для выведения избытка железа из организма используются хелатирующие средства (дефероксамин). Этот препарат обычно назначается вместе с аскорбиновой кислотой, так как она потенцирует хелатирующее действие дефероксамина. Из-за постоянного гемолиза у больных повышен расход фолатов, поэтому им показан длительный прием больших доз фолиевой кислоты.
Хирургическое лечение
Для ряда пациентов с выраженными признаками гемолиза эффективным лечением является спленэктомия – оперативное удаление селезенки. Другой хирургический вид лечения, позволяющий добиться полной ремиссии – аллотрансплантация гемопоэтических стволовых клеток. Однако этот метод применяется редко, только в очень тяжелых случаях, так как он сопряжен с высокой частотой летальных исходов. При холелитиазе выполняется холецистэктомия.
Экспериментальное лечение
В настоящее время ведутся клинические исследования по поиску лекарства для излечения гемоглобинопатий. Есть успешные результаты генной терапии СКА. Суть лечения заключается во введении в стволовые клетки пациента гена, кодирующего синтез нормальной бета-глобиновой цепи, с помощью обезвреженного лентивируса. Препарат называется LentiGlobin BB305. Его применение привело к улучшению показателей крови, что позволило отказаться от постоянной стандартной терапии. Также проводятся испытания данного препарата при бета-талассемии.
Прогноз и профилактика
Гемоглобинопатии являются тяжелыми заболеваниями с опасными жизнеугрожающими осложнениями. Пациенты с гомозиготной альфа-талассемией умирают еще до рождения в утробе матери. Больные бета-талассемией погибают до наступления пубертатного возраста от сердечной недостаточности. Люди, имеющие качественные гемоглобинопатии, при грамотном лечении могут прожить дольше 50 лет. Основная причина смерти – бактериальные инфекции, тромботические осложнения. При гетерозиготных формах заболевания в большинстве случаев продолжительность жизни не отличается от общей популяции.
Первичная профилактика проводится среди семей, имеющих высокий риск развития гемоглобинопатий. Она заключается в пренатальной диагностике с прерыванием беременности по медпоказаниям. Пациенты, страдающие качественными аномалиями гемоглобина, обязательно должны получить вакцину от гемофильной палочки, пневмококка, менингококка. Детям от 4 месяцев до 6 лет показано длительное применение пенициллиновых антибиотиков для профилактики инфекций. То же касается больных, перенесших спленэктомию.
Талассемия
Талассемия – наследственные гемоглобинопатии, характеризующиеся угнетением синтеза цепочечных белковых молекул, образующих структуру гемоглобина. Это приводит к повреждению мембраны эритроцитов и разрушению красных клеток крови с развитием гемолитических кризов. Признаками талассемии служат характерные костные изменения, гепатоспленомегалия, анемический синдром. Диагноз талассемии подтверждается клиническими и лабораторными данными (исследованием гемограммы, гемоглобина, миелограммы, электрофоретическим методом). Возможна пренатальная диагностика талассемии. В лечении талассемии применяются гемотрансфузии, терапия десфералом, спленэктомия, трансплантация костного мозга.



Талассемия – группа генетически детерминированных болезней крови, развивающихся при нарушении синтеза a- или β-цепей гемоглобина, сопровождающихся гемолизом, гипохромной анемией, микроцитозом. В гематологии талассемия относится к наследственным гемолитическим анемиям - количественным гемоглобинопатиям.
Талассемия широко распространена среди населения Средиземноморского и Черноморского региона; название заболевания буквально переводится как «анемия морского побережья». Также случаи талассемии нередки в странах Африки, Ближнего Востока, Индии и Индонезии, Средней Азии и Закавказья. С синдромом талассемии каждый год в мире рождается 300 тыс. детей. В зависимости от формы патологии течение талассемии может быть тяжелым, фатальным или легким, бессимптомным. Так же, как серповидно-клеточная анемия, талассемия играет роль защитного фактора против малярии.
Причины талассемии
Талассемия является генетическим заболеванием с аутосомно-рецессивным наследованием. Непосредственной причиной патологии выступают различные мутационные нарушения в гене, кодирующем синтез той или иной цепи гемоглобина. Молекулярную основу дефекта могут составлять синтез аномальной матричной РНК, делеции структурных генов, мутации регуляторных генов либо их неэффективная транскрипция. Следствием подобных нарушений служит снижение или отсутствие синтеза одной из полипептидных гемоглобиновых цепей.
Так, при b-талассемии бета-цепи синтезируются в недостаточном количестве, что приводит к избытку альфа-цепей, и наоборот. Избыточно продуцируемые полипептидные цепи откладываются в клетках эритроидного ряда, вызывая их повреждение. Это сопровождается деструкцией эритрокариоцитов в костном мозге, гемолизом эритроцитов в периферической крови, гибелью ретикулоцитов в селезенке. Кроме этого, при b-талассемии в эритроцитах накапливается фетальный гемоглобин (НbF), не способный транспортировать кислород в ткани, что вызывает развитие тканевой гипоксии. Вследствие костномозговой гиперплазии развивается деформация костей скелета. Анемия, тканевая гипоксия и неэффективный эритропоэз в той или иной степени нарушают развитие и рост ребенка.
Для гомозиготной формы талассемии характерно наличие двух дефектных генов, унаследованных от обоих родителей. При гетерозиготном варианте талассемии пациент является носителем мутантного гена, унаследованного от одного из родителей.
С учетом поражения той или иной полипептидной цепи гемоглобина различают:
- a-талассемию (с подавлением синтеза альфа-цепей HbA). Данная форма может быть представлена гетерозиготным носительством манифестного (α-th1) или немого (α-th2) гена; гомозиготной a-талассемией (водянкой плода с гемоглобином Бартса); гемоглобинопатией Н
- b-талассемию (с подавлением синтеза бета-цепей HbA). Включает в себя гетерозиготную и гомозиготную β-талассемию (анемию Кули), гетерозиготную и гомозиготную δβ-талассемию (F-талассемию)
- γ-талассемию (с подавлением синтеза гамма-цепей гемоглобина)
- δ-талассемию (с подавлением синтеза дельта-цепей гемоглобина)
- талассемию, обусловленную нарушением структуры гемоглобина.
Симптомы талассемии
Признаки большой (гомозиготной) b-талассемии проявляются уже в течение 1-2-го года жизни ребенка. Больные дети имеют характерное монголоидное лицо, седловидную переносицу, башенный (четырехугольный) череп, гипертрофию верхней челюсти, нарушение прикуса, гепато- и спленомегалию. Проявлениями анемизации служат бледный или землисто-желтушный цвет кожных покровов.
Поражение трубчатых костей сопровождается отставанием в росте и патологическими переломами. Возможно развитие синовита крупных суставов, калькулезного холецистита, язв нижних конечностей. Фактором, осложняющим течение b-талассемии, выступает гемосидероз внутренних органов, приводящий к развитию цирроза печени, фиброза поджелудочной железы и, как следствие, - сахарного диабета; кардиосклероза и сердечной недостаточности. Больные восприимчивы к инфекционным заболеваниям (кишечным инфекциям, ОРВИ и др.), возможно развитие тяжелых форм пневмонии и сепсиса.
Малая (гетерозиготная) b-талассемия может протекать бессимптомно или с минимальными клиническими проявлениями (умеренным увеличением селезенки, незначительно выраженной гипохромной анемией, жалобами на повышенную утомляемость). Аналогичная симптоматика сопровождает течение гетерозиготной формы a-талассемии.
При гомозиготной форме a-талассемии альфа-цепи полностью отсутствуют; фетальный гемоглобин у плода не синтезируется. Данная форма талассемии несовместима с жизнью, что приводит к внутриутробной гибели плода вследствие развивающегося синдрома водянки или самопроизвольному прерыванию беременности. Течение гемоглобинопатии Н характеризуется развитием гемолитической анемии, спленомегалии, тяжелых костных изменений.

Талассемию следует заподозрить у лиц с семейным анамнезом, характерными клиническими признаками и лабораторными показателями. Больные талассемией нуждаются в консультации гематолога и медицинского генетика.
Типичными гематологическими изменениями служат снижение уровня гемоглобина и цветового показателя, гипохромия, наличие мишеневидных эритроцитов, повышение уровня железа сыворотки крови и непрямого билирубина. Электрофорез Hb на ацетат-целлюлозной пленке используется для определения различных гемоглобиновых фракций. При изучении пунктата костного мозга обращает внимание гиперплазия красного кроветворного ростка с высоким числом эритробластов и нормобластов. Молекулярно-генетические исследования позволяют выявить мутацию в локусе a- или β-глобина, нарушающую синтез полипептидной цепи.
На краниограммах при большой b-талассемии выявляется игольчатый периостоз (феномен «волосатого черепа»). Характерна поперечная исчерченность трубчатых и плоских костей, наличие мелких очагов остеопороза. С помощью УЗИ брюшной полости обнаруживается гепатоспленомегалия, камни желчного пузыря.
При подозрении на талассемию требуется исключить железодефицитную анемию, наследственный микросфероцитоз, серповидно-клеточную анемию, аутоиммунную гемолитическую анемию. В семьях, имеющих больных талассемией, рекомендуется проведение генетического консультирования супругов и инвазивной дородовой диагностики (биопсии хориона, кордоцентеза, амниоцентеза) для выявления гемоглобинопатии на ранних сроках беременности. Подтверждение гомозиготных форм талассемии у плода служит показанием для искусственного прерывания беременности.
Лечение талассемии
Лечебная тактика при различных формах талассемии неодинакова. Так, пациенты с малой b-талассемией в лечении не нуждаются. С другой стороны, больным с гомозиготной b-талассемией с первых месяцев жизни требуется проведение гемотрансфузионной терапии (переливание размороженных или отмытых эритроцитов), введение хелатирующих препаратов, связывающих железо (дефероксамина), глюкокортикоидов при возникновении гемолитических кризов. При всех формах талассемии показан прием препаратов фолиевой кислоты и витаминов группы В.
При гиперспленизме (особенно на фоне гемоглобиноза Н) требуется удаление селезенки (спленэктомия). Из-за склонности к присоединению инфекционных осложнений больным рекомендуется обязательная вакцинация против пневмококковой инфекции. Многообещающим методом лечения талассемии служит трансплантация костного мозга от гистосовместимого донора.

Прогноз
Прогноз больших форм талассемии неблагоприятный; больные погибают в младенческом или молодом возрасте. При гетерозиготной бессимптомной форме талассемии продолжительность и качество жизни в большинстве случаев не страдают. Первичная профилактика талассемии включает предупреждение браков между гетерозиготными носителями генов заболевания, а при высоком генетическом риске рождения больного потомства – отказ от деторождения.
Читайте также:
